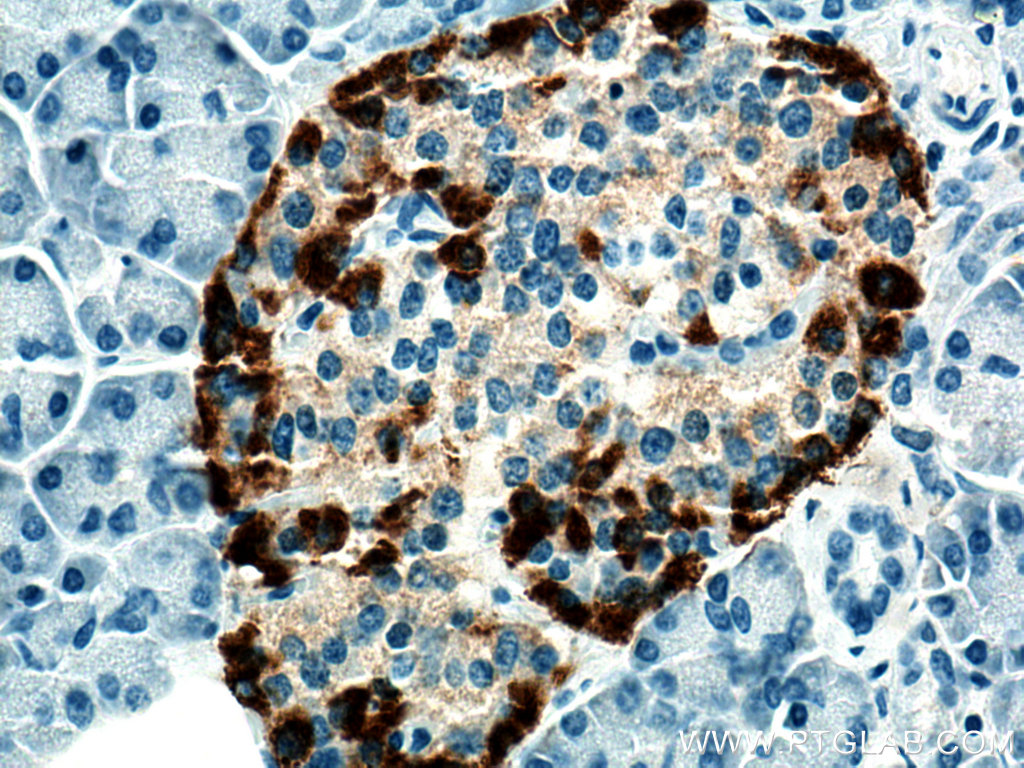

验证数据展示
经过测试的应用
| Positive IHC detected in | human pancreas tissue, mouse pancreas tissue Note: suggested antigen retrieval with TE buffer pH 9.0; (*) Alternatively, antigen retrieval may be performed with citrate buffer pH 6.0 |
| Positive IF-P detected in | mouse pancreas tissue, human pancreas tissue |
推荐稀释比
| 应用 | 推荐稀释比 |
|---|---|
| Immunohistochemistry (IHC) | IHC : 1:2000-1:15000 |
| Immunofluorescence (IF)-P | IF-P : 1:200-1:800 |
| It is recommended that this reagent should be titrated in each testing system to obtain optimal results. | |
| Sample-dependent, Check data in validation data gallery. | |
产品信息
67286-1-Ig targets Glucagon in WB, IHC, IF-P, ELISA applications and shows reactivity with human, mouse samples.
| 经测试应用 | IHC, IF-P, ELISA Application Description |
| 文献引用应用 | WB, IHC, IF |
| 经测试反应性 | human, mouse |
| 文献引用反应性 | human, mouse |
| 免疫原 |
CatNo: Ag10629 Product name: Recombinant human Glucagon protein Source: e coli.-derived, PET28a Tag: 6*His Domain: 1-180 aa of BC005278 Sequence: MKSIYFVAGLFVMLVQGSWQRSLQDTEEKSRSFSASQADPLSDPDQMNEDKRHSQGTFTSDYSKYLDSRRAQDFVQWLMNTKRNRNNIAKRHDEFERHAEGTFTSDVSSYLEGQAAKEFIAWLVKGRGRRDFPEEVAIVEELGRRHADGSFSDEMNTILDNLAARDFINWLIQTKITDRK 种属同源性预测 |
| 宿主/亚型 | Mouse / IgG1 |
| 抗体类别 | Monoclonal |
| 产品类型 | Antibody |
| 全称 | glucagon |
| 别名 | GCG, 2A8G1, Glicentin-related polypeptide, Glucagon-like peptide 1, Glucagon-like peptide 1(7-36) |
| 计算分子量 | 180 aa, 21 kDa |
| GenBank蛋白编号 | BC005278 |
| 基因名称 | Glucagon |
| Gene ID (NCBI) | 2641 |
| RRID | AB_2882552 |
| 偶联类型 | Unconjugated |
| 形式 | Liquid |
| 纯化方式 | Protein G purification |
| UNIPROT ID | P01275 |
| 储存缓冲液 | PBS with 0.02% sodium azide and 50% glycerol, pH 7.3. |
| 储存条件 | Store at -20°C. Stable for one year after shipment. Aliquoting is unnecessary for -20oC storage. |
背景介绍
Glucagon is a 29-amino acid peptide hormone secreted from the pancreatic alpha cells with a powerful stimulatory effect on hepatic glucose production acting to increase plasma glucose levels. Glucagon is best known as the counter-regulatory hormone to INS, and normal glucose homeostasis depends largely on the balanced secretion of INS and glucagon from the pancreatic beta and alpha cells, respectively.The regulation of glucose metabolism by glucagon is mediated by its direct action on the peripheral tissues such as the liver and also by the brain. Glucagon is also released postprandially in a transient manner, which was shown to be involved in inhibition of food intake via reduction of meal size.
实验方案
| Product Specific Protocols | |
|---|---|
| IF protocol for Glucagon antibody 67286-1-Ig | Download protocol |
| IHC protocol for Glucagon antibody 67286-1-Ig | Download protocol |
| Standard Protocols | |
|---|---|
| Click here to view our Standard Protocols |
发表文章
| Species | Application | Title |
|---|---|---|
Food Chem X Dendrobium officinale leaf polysaccharides ameliorated hyperglycemia and promoted gut bacterial associated SCFAs to alleviate type 2 diabetes in adult mice. | ||
Life Sci Alliance ciBAR1 loss in mice causes laterality defects, pancreatic degeneration, and altered glucose tolerance | ||
Mol Cell Endocrinol Mof acetyltransferase inhibition ameliorates glucose intolerance and islet dysfunction of type 2 diabetes via targeting pancreatic α-cells. | ||
Life Sci Semaglutide alleviates the pancreatic β cell function via the METTL14 signaling and modulating gut microbiota in type 2 diabetes mellitus mice | ||
Acta Pharm Sin B A critical role for Phocaeicola vulgatus in negatively impacting metformin response in diabetes | ||
J Agric Food Chem Bifidobacterium longum subsp. longum B-53 Alleviated Abnormalities of Glycolipid Metabolism and Oxidative Stress in T2DM Mice Through Regulating Gut Microbiota and GLP-1 Secretion |